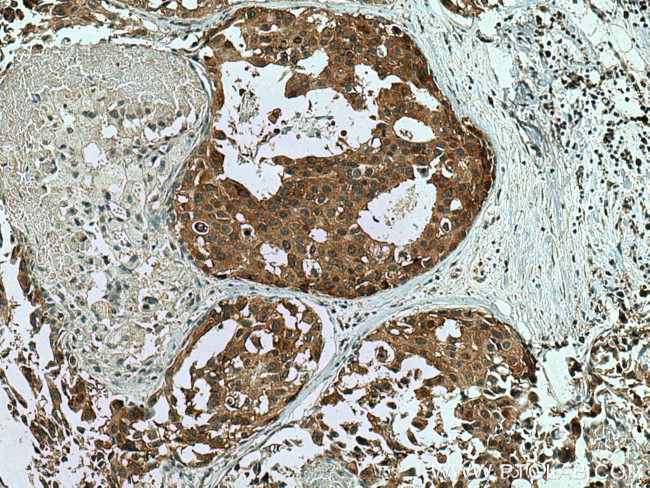
WIPF2 Antibody in Immunohistochemistry (Paraffin) (IHC (P))

Search
Proteintech
WIPF2 Polyclonal Antibody
{{$productOrderCtrl.translations['antibody.pdp.commerceCard.promotion.promotions']}}
{{$productOrderCtrl.translations['antibody.pdp.commerceCard.promotion.viewpromo']}}
{{$productOrderCtrl.translations['antibody.pdp.commerceCard.promotion.promocode']}}: {{promo.promoCode}} {{promo.promoTitle}} {{promo.promoDescription}}. {{$productOrderCtrl.translations['antibody.pdp.commerceCard.promotion.learnmore']}}
产品信息
20512-1-AP
种属反应
宿主/亚型
分类
类型
抗原
偶联物
形式
浓度
规格
纯化类型
保存液
内含物
保存条件
运输条件
产品详细信息
Immunogen sequence: TFHQANTEQ PKLSRDEQRG RGALLQDICK GTKLKKVTNI NDRSAPILEK PKGSSGGYGS GGAALQPKGG LFQGGVLKLR PVGAKDGSEN LAGKPALQIP SSRAAAPRPP VSAASGRPQD DTDSSRASLP ELPRMQRPSL PDLSRPNTTS STGMKHSSSA (18-176 aa encoded by BC065551)
靶标信息
This gene belongs to the GPI family whose members encode multifunctional phosphoglucose isomerase proteins involved in energy pathways. The protein encoded by this gene is a dimeric enzyme that catalyzes the reversible isomerization of glucose-6-phosphate and fructose-6-phosphate. The protein functions in different capacities inside and outside the cell. In the cytoplasm, the gene product is involved in glycolysis and gluconeogenesis, while outside the cell it functions as a neurotrophic factor for spinal and sensory neurons. Defects in this gene are the cause of nonspherocytic hemolytic anemia and a severe enzyme deficiency can be associated with hydrops fetalis, immediate neonatal death and neurological impairment.
仅用于科研。不用于诊断过程。未经明确授权不得转售。
篇参考文献 (0)
生物信息学
蛋白别名: unnamed protein product; WAS/WASL-interacting protein family member 2; WASP-binding protein; WASP-interacting protein-related protein; WIP- and CR16-homologous protein; WIP-related protein
基因别名: 1110014J05Rik; 5730509C05Rik; AA407487; Gm1176; PP10631; RGD1561080; WICH; WIPF2; WIRE
UniProt ID: (Human) Q8TF74, (Mouse) Q6PEV3
Entrez Gene ID: (Human) 147179, (Mouse) 68524, (Rat) 360620